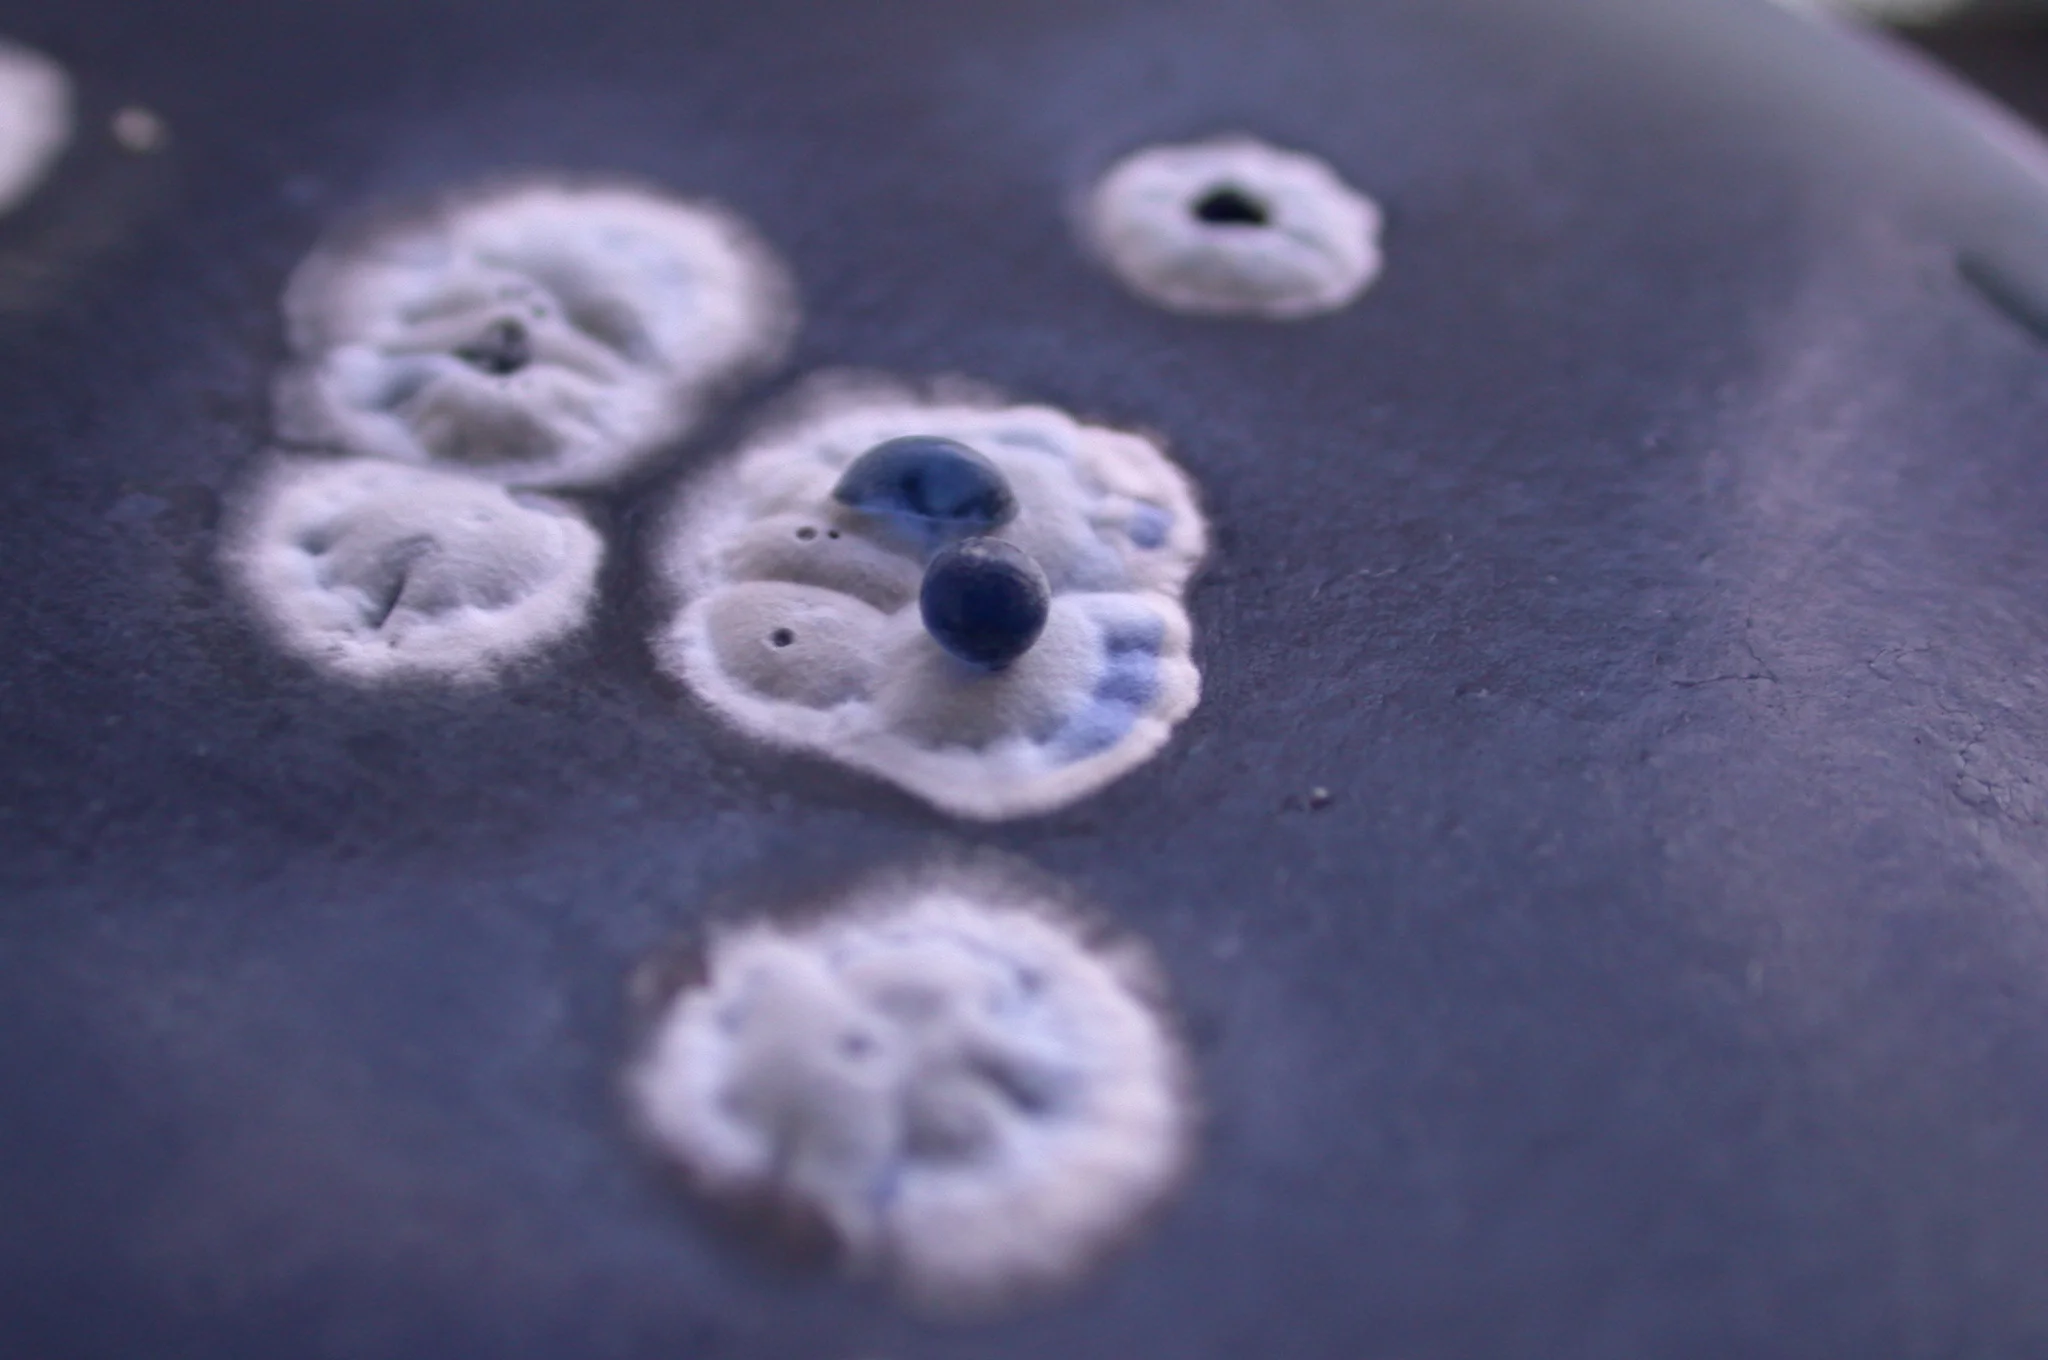
Targeting bacteria through host induced gene silencing

Host induced gene silencing (HIGS) is a powerful technique which expresses interfering RNAs from a plant which, for example, have been used to knockdown genes responsible for aflatoxin production in Aspergillius flavis. Nobody however has used HIGS to target bacteria, neither symbiotes living in the rhizosphere or pathogens such as Streptomyces scabies. I am hoping to employ a lethal host induced gene silencing strategy to achieve three things; to aid my research in understanding the rhizospheric microbial ecology by targeting possible keystone species with lethal RNAi, to generate strains of Solanum tuberosum insusceptible to infection by S. scabies and potentially to manipulate plant associated microbiomes to benefit crop yields and disease resistance.
Contact colette.matthewman@jic.ac.uk if you would be interested in joining a team for this proposal.
Image: Streptomyces coelicolor by Matt Hutchings, University of East Anglia. Shared under CC BY 4.0 on the Norwich Research Park Image Library.